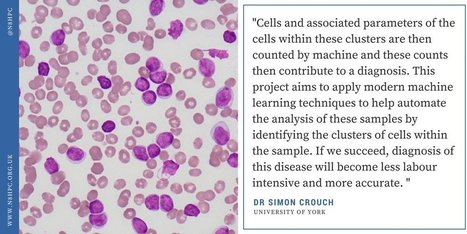
Analysis of Flow Cytometry Data from Patients with Chronic Lymphocytic Leukaemia | N8HPC | from Flow Cytometry to Cytomics | Scoop.it

Dr Simon Crouch, University of York Chronic Lymphocytic Leukaemia (CLL) is a disease of the blood that is currently diagnosed by the analysis of a blood sample. Flow cytometry is used to measure various parameters about blood cells from the sample that are known to be associated with CLL.
Follow, research and publish the best content
Get Started for FREE
Sign up with Facebook Sign up with X
I don't have a Facebook or a X account
Already have an account: Login
 Your new post is loading... Your new post is loading...
 Your new post is loading... Your new post is loading...
|